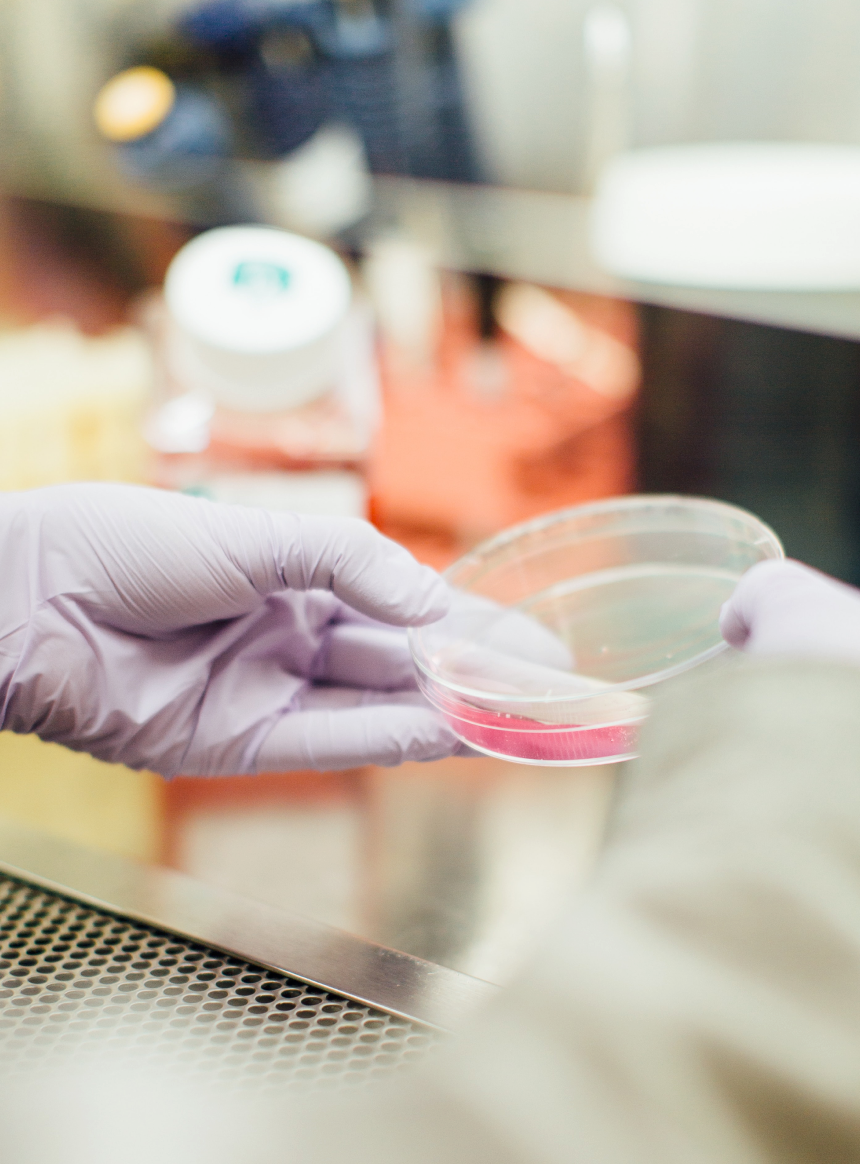

ABOUT US

Our Philosophy
We believe in cherishing the little luxuries in life, while still investing in the future. Caring for the health of our planet and your skin is just the beginning.
Science & Research
We enhance the healing powers of Mother Nature with patented technology, fusing clean ingredients and advanced formulations inside every bottle. Fall in love at first touch with our hydrating formulas, filled with potent actives to leave you brimming with confidence.
